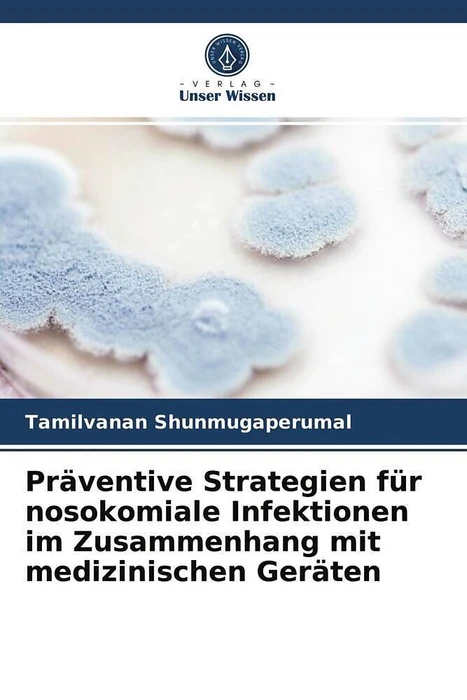

Wir verwenden Cookies und Analyse-Tools, um die Nutzerfreundlichkeit der Internet-Seite zu verbessern und für Marketingzwecke. Wenn Sie fortfahren, diese Seite zu verwenden, nehmen wir an, dass Sie damit einverstanden sind. Zur Datenschutzerklärung.
Präventive Strategien für nosokomiale Infektionen im Zusammenhang mit medizinischen Geräten
Details
Nach der Implantation oder Einbringung in den Körper des Patienten zur Ausübung des beabsichtigten Zwecks, wie die Rettung der normalen Funktionen lebenswichtiger Organe, werden die medizinischen Geräte leider zum Schauplatz der Konkurrenz zwischen der Integration der Wirtszellen und der mikrobiellen Adhäsion. Zur Kontrolle der mikrobiellen Besiedlung und der anschliessenden Biofilmbildung auf den medizinischen Geräten werden verschiedene Ansätze erforscht, um entweder die Effizienz bestimmter antimikrobieller Mittel zu erhöhen oder die grundlegende Physiologie der pathogenen Mikroorganismen zu stören, einschliesslich neuartiger kleiner Moleküle und antipathogener Medikamente. Darüber hinaus werden auch die verschiedenen lipid- und polymerbasierten Arzneistoffträger untersucht, um eine Antibiofilmbeschichtung auf die medizinischen Geräte, insbesondere über Katheter, aufzubringen. Dieses Buch fasst die wichtigsten und/oder bahnbrechenden Erfindungen zusammen, die in der Patentliteratur sowie in Forschungsarbeiten im Zusammenhang mit den Präventivstrategien für Infektionen mit Medizinprodukten offenbart wurden. Mit dieser Abdeckung bietet dieses Buch eine Reihe von Strategien, die dem medizinischen Wissenschaftler zur Verfügung stehen, um ein medizinisches Gerät mit Antibiofilm-Eigenschaften zu entwickeln.
Autorentext
Tamilvanan Shunmugaperumal, Ph.D.: Studierte Pharmazie an der Universität Annamalai, der Medizinischen Hochschule von Madras und der Universität Jadavpur, Indien. Postdoc-Stipendiatin an der Hebräischen Universität Jerusalem, Israel, und der Universität Antwerpen, Belgien. Derzeit arbeitet er an der Internationalen Medizinischen Universität, Kuala Lumpur, Malaysia.
Weitere Informationen
- Allgemeine Informationen
- GTIN 09786202874120
- Sprache Deutsch
- Genre Sonstige Wirtschaftsbücher
- Größe H220mm x B150mm x T14mm
- Jahr 2021
- EAN 9786202874120
- Format Kartonierter Einband
- ISBN 978-620-2-87412-0
- Veröffentlichung 22.01.2021
- Titel Präventive Strategien für nosokomiale Infektionen im Zusammenhang mit medizinischen Geräten
- Autor Tamilvanan Shunmugaperumal
- Gewicht 328g
- Herausgeber Verlag Unser Wissen
- Anzahl Seiten 208